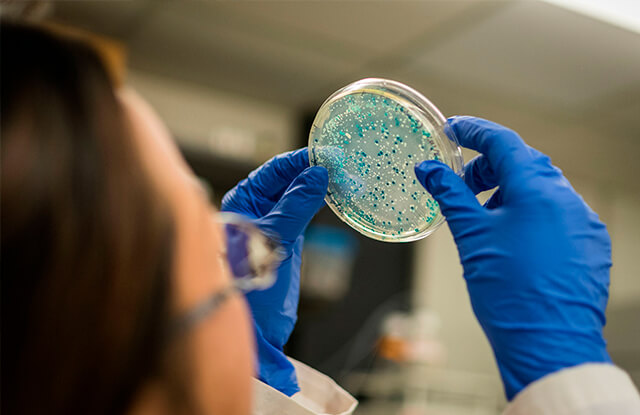

Conheça o Laboratório
Bem vindo ao Laboratório Hemocel
Inovação, excelência técnica e qualidade de serviços.
A Hemocel Medicina Laboratorial reúne profissionais qualificados e tecnologia avançada para atender seus pacientes com conforto, modernidade, privacidade e agilidade.
Nossos Exames
Uma gama de Exames Laboratoriais de qualidade, disponíveis para coleta no conforto de sua casa.